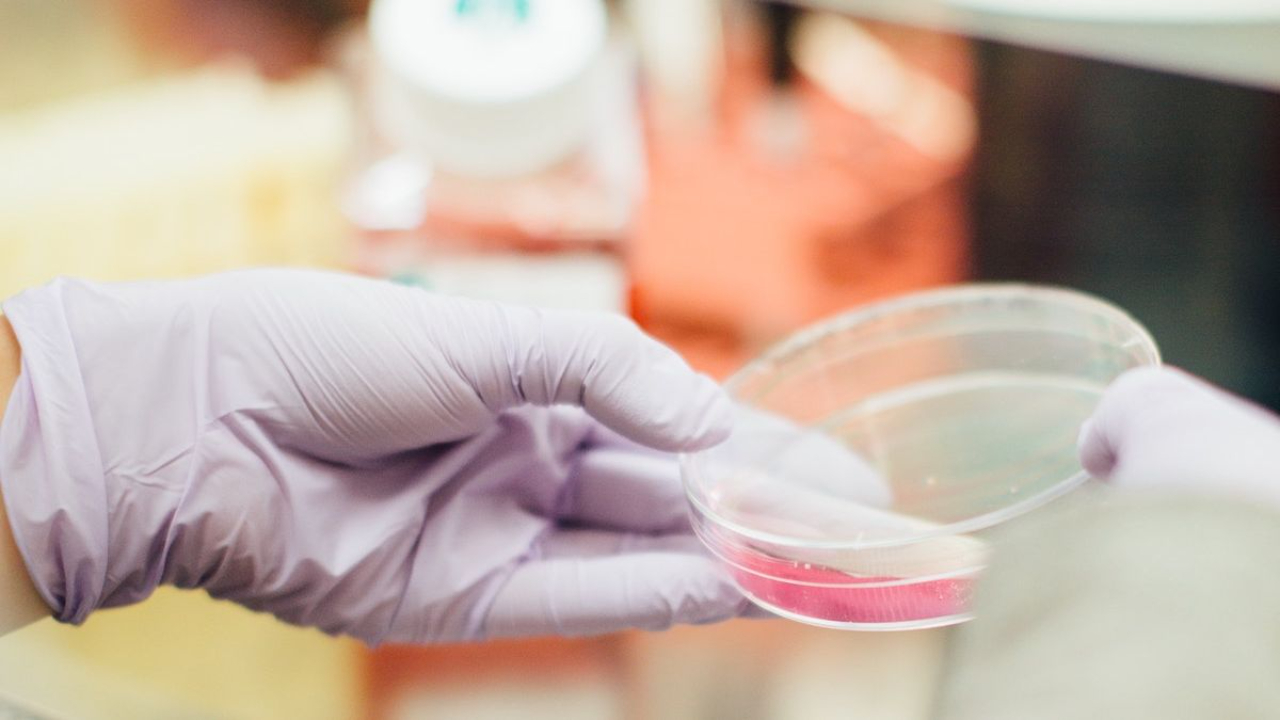

Fashion Product Testing: Basic Tests you Should be Doing Regularly
Fashion product testing enables brands, retailers and manufacturers to ensure the safety, quality and performance of their goods.
Tests can be carried out on items ranging from fabric samples to finished products, including active-wear, apparel for adults and children such as sweaters, sleepwear, outerwear and jeans.
Footwear and fashion accessories such as scarves, belts and bags are also tested. Lest we forget fastenings such as buttons and zips as even these have to be quality and safety assured in order to ensure they’re fit for purpose. These tests are carried out in adherence to a set of Standards which are derived from the combined wisdom of experts in their field.
In every major consumer market, an ever-increasing range of stringent regulations and restrictions for textiles and apparel products are being imposed or are under negotiation. Your products are required to comply with local statutory laws and regulations if you want to sell in a particular market.
Furthermore, fashion product testing enables the reduction of risks such as product recalls, helps protect your brand and gain the trust of the consumer.
Basic Tests to Perform on Garments and Apparel
Breaking Strength test
What: The breaking strength test is multidirectional and is predominantly used on woven fabrics. Breaking strength is expressed in pounds and elongation is expressed as a percentage. In both cases, a number of warp and weft tests are performed.
Why: This test is used on garments to check the effects of sunlight, wear and tear and laundering.
Bursting Strength test
What: This test determines the amount of pressure that is required to rupture a fabric. It is used on non-woven fabrics such as knits, lace and felt. The bursting strength is expressed in pounds.
Why: Another method of testing fabric strength, particularly applicable for performance wear such as sportswear and uniforms.
Pilling tests
What: Fabrics and clothing regularly come into contact with surfaces that can damage their appearance. Regular wear and washing can cause pilling on the top layer (A pill, colloquially known as a bobble, fuzzball, or lint ball is a small ball of fibres that forms on a piece of cloth. Pilling is a surface defect of textiles caused by wear, and is considered unsightly to some.).
Evaluation should be made by considering the size, number and visibility of the piling as well as the type and degree of other surface change. After the tests, each specimen is evaluated on a 5-4-3-2-1 piling scale with the colour change and degree of fuzz on the surface appearance noted.
Why: Mostly performed on knitted textiles, these tests give ideas as to the end quality of the material and potential customer returns.
Abrasion resistance
What: When materials rub against each other abrasion resistance occurs. Garments that are made from fibres that possess both high breaking strength and abrasion resistance, such as nylon, can be worn regularly before signs of physical wear appear.
Fabrics such as acetate, which is used extensively for lining garments, has poor abrasion resistance so doesn’t last very long.
Why: Customer satisfaction and return rates related test.
Colourfast testing
What: This is used to determine the resistance to colour change, under various conditions, of dyed or printed fabrics. A cloth material that is brighter with deeper colours tends to be affected more than fabrics in lighter shades.
Certain elements determine whether textile colours will be affected. These include exposure to sunlight, pollution, perspiration, crocking, washing and dry cleaning.
Why: Customer satisfaction and return rates related test.
AATCC Colourfast Test Methods and Standards
The American Association of textile chemists and colourists has a set of test methods and standards that are used in industry to test materials and garments. These tests run into the hundreds and can be purchased through their website for £30 to members and £50 to non-members (prices are correct at time of publishing this article), per test and can then be carried out on your premises. The test methods are delivered via a link in your emailed receipt. The basic tests include the following:
- Colourfastness to Light T16.1
This test method provides the general principles and procedures for determining the colourfastness to light of textile materials outdoors under glass. The test options described are applicable to textile materials of all kinds and for colourants, finishes and treatments applied to textile materials.
- Colourfastness to Crocking: Crock metre Method TM008
This test was originally developed in the 1930’s and revised in 2016.
Crocking is the transfer of dye from the surface of a dyed or printed fabric onto another surface by rubbing. The more colour is transferred, the more the fabric "crocks". Crocking determines the amount of colour transferred from the surface of coloured textile materials to other surfaces by rubbing.
Dye crocking is the result of colour loss by mechanical actions such as friction and abrasion. Crocking can be the result of a lack of penetration of the dyeing agent, the use of incorrect dyes or dyeing procedures, or the lack of proper washing procedures and finishing treatments after the dyeing process. If the textile dying or printing process is not done properly, the rubbing-off of dye from a fabric may occur.
Test procedures employing white test cloth squares, both dry and wet with water, are supplied. Considering that washing, dry cleaning, shrinkage, ironing, finishing, etc., may affect the degree of colour transfer from a material, the test may be made before, after, or before and after any such treatment. The testing method includes the rubbing of a coloured test specimen with a white crock test cloth under controlled conditions. Any colour that is transferred to the white test cloth is assessed by a comparison with the Gray Scale for Staining or the Chromatic Transference Scale and a grade is assigned.
Leather Goods Tests
Leather goods testing is necessary to ensure that products made in this durable material are genuine, free of hazardous chemicals and can withstand everyday use. Testing methods and Leather Standards are similar to those set for the testing of textile garments.
The ASTM has formulated a set of standards for testing leather and leather goods. Each standard costs £30 and can be downloaded from their website The basic tests used for the fashion product testing of leather goods include the following:
Tear Strength test
What: The Baumann method was developed specially for testing leather garments. A defined shape is cut out of each leather specimen. Specialist jaws are fitted to a tensile testing machine which allows a load to be applied pulling across the cut-out in the leather sample. Two tears are generally produced- one from each end of the cut-out.
The Lastometer (Standard Test Method for Bursting Strength of Leather by the Ball Method ASTM D2207) test method was formulated to measure the bursting strength of leather shoe uppers by measuring the force required to introduce a spherical ended plunger through a piece of leather. The bursting load and extension will be proportional to the plunger diameter. The ball test method can be used to test a large variety of leathers and products and is applicable to light and medium weight leathers.
Why: These are"fit for purpose" performance and safety-related tests. They also relate to customer satisfaction and return rates.
Standard Test Method for Resistance of Coloured Leather to Bleeding
ASTM D5552
What: Bleed resistance is an important characteristic in leather and this test is used to determine whether any colour bleeds will occur from the surface of the leather when it comes into contact with water. The test method is intended for use on finished articles such as shoes and handbags.
Why: Customer satisfaction and return rates related test.
Lightfastness test
What: Fading is one of the main causes of damage to leather objects.
Aniline-coloured porous leathers tend to fade faster than more engineered pigmented leather. The light fastness of leather - as well as with textiles - is measured by means of the so-called blue scale test. Eight blue wool strips of descending light fastness are placed together with a sample of the leather to be tested in ultraviolet light. A part of the sample surface and a part of the wool strip surface is covered and compared after the exposure. The Xenon test simulates sunlight and is used to measure the fading sensitivity of leather.
Why: Customer satisfaction and return rates related test. It is important to know how a material will perform before you invest in it being made into a final product. For example, for more expensive leather goods like handbags that will be exposed daily to sunlight, knowing that they will not discolour quickly and lead to customer dissatisfaction and high return rates is of utmost importance.
Wet and Dry Rub Fastness test
What: This test determines whether the colour will rub off the leather products onto other items under wet and dry conditions.
A white wool felt material would be loaded onto a machine and rubbed repeatedly over a stretched leather surface several times. The leather and felt are then tested for changes. The felt is tested for colour transference from the leather and the leather is tested for damage and fading.
Why: Customer satisfaction and return rates related test. Especially with handbags worn under the arm or handheld and rubbing against clothes.
-
Acceptance criteria
With all of the above tests, a minimum of three specimens should be tested for tolerance. All of the results should then be recorded and an average is taken from the three.
How to find fashion product testing centres?
Testing centres operate worldwide, which makes sourcing them easy.
However, selecting the best one for your particular needs could prove a little trickier.
- The AATCC (for textiles products) and the ASTM (for leather goods) as previously mentioned, provide kits for testing. Some of the tests that do not need specialist machinery can be carried out at home. Other tests that require the use of a specialist machine can be found at companies such as Satra Technology which produces the testing equipment and also provides a testing service for footwear and apparel.
- Precision Testing Laboratories provide Test Request Forms which can be downloaded from their website, filled out and returned to the company along with your samples.
- The British Leather Centre (BLC), based in Northampton, UK is an excellent resource that not only provides the Test Request service but also has a small tannery on their premise and organises 1-3+ day courses educating brands, designers and businesses on various aspects of technicalities and standard requirements the industry expects to be met.
In the competitive field of fashion, it’s important to stand out for the right reasons. Don’t let a light shine on your company because of inferior products.
It’s in the interests of all brands no matter how big or small to ensure that their goods will meet basic quality control criteria before their introduction to the market.


